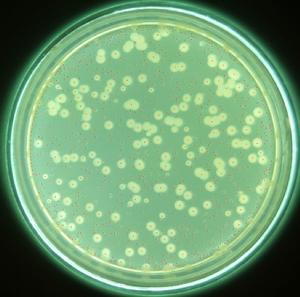
銅綠假單胞菌

概述
 治病細菌
治病細菌歷史發展
60年前抗生素耐藥菌就已出現在世間。自那時起,科學家就一直在孜孜不倦地研發第二代藥物。這種藥物攻擊的靶點並非細菌本身,而是想切斷細菌與細菌之間的通訊聯繫。然而細菌的複雜性又一次超過了人們的預期,這使得相關的進展十分緩慢。如今社會進化生物學領域的一些發現或許能夠幫助我們最終發現一種擊敗致病微生物的方法——通過“策反”其中一些成員,繼而摧毀整個致病菌群體。40年前,科學家發現一些細菌能夠以某些小分子為媒介,向周圍的細菌傳送或接受來自它們的信息。這種被稱之為“群體感應(quorum sensing)”的通訊方式使得細菌可以偵測它們的群體密度,並據此調整自身的行為。當周圍有夠多的成員足以形成一個“群體”時,細菌便開始產生一種導致宿主患病的有毒因子。這些細菌還可以聚集起來形成生物膜,這使得它們耐受抗生素的能力提高了1000倍。
研究策略
 細菌
細菌現在的問題是效果良好的群體感應抑制劑難覓蹤影。致病菌用於通訊的分子往往具有種屬特異性,這使得研發廣譜的抑制劑變得非常困難,而且目前在動物實驗中證實有良好效果的抑制劑對人體卻具有不小的毒性。一些研究者還擔心,這些藥物可能僅在群體形成之前,也就是在感染的起始階段才有效。面對這些重重障礙,很少有製藥公司願意投資到這些領域的藥物研發。美國威斯康辛-麥迪遜大學的化學家Helen Blackwell評論道人們對這種藥物有點小心翼翼。
研究突破
在2009年1月,Edinburgh大學的進化生物學家Stuart West與其同事宣布,他們基於一個群體感應的細微差別,設計出一條新思路。此前人們就知道,一個菌群中並非所有的細菌都能正常地進行通訊。信號接收系統發生突變的細菌只能產生低水平的信號分子,而且無法接收信號,而信號傳送系統發生突變的細菌恰好相反。這些突變細菌還能從群體感應中得到好處,因為它們的鄰居在生產信號分子以及接受和傳送信號的時候需要消耗能量,而突變體則會節省很多。因此後者複製更快,數目也會變得更多。這使得突變體的後代占整個群體的比例越來越大。不過一旦突變體的比例過高,群體間的通訊就會變得十分稀少,不足以達到群體感應的臨界點,從而菌群的致病性就會下降。
重要試驗
銅綠假單胞菌
銅綠假單胞菌West承認這種療法短時間內付諸實用尚不太可能。一方面利用更多的細菌來治療細菌感染,這讓病人接受起來相當困難,更別提管理機構了。不過他和同事還是為這一療法申請了專利。他們試圖利用突變體向一個菌群導入一些特定基因,為此他們仍在尋找相關的“特洛伊木馬”。West解釋道假設你被細菌感染,這種細菌恰好對抗生素存在抗性,那么首先讓一些對抗生素敏感的間諜細菌混入正常菌群,然後讓這種敏感性在菌群中擴散,很快利用現有的藥物就可以對付整個菌群了。

